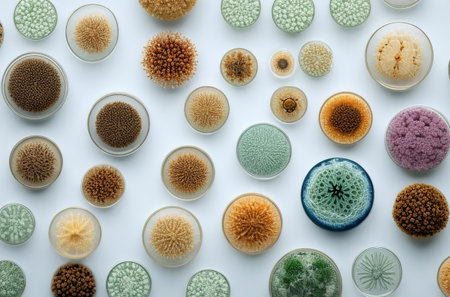
Microbial Colonies: Unveiling the Secrets of Microbiological Science. Generative AI.の素材

素材 - Microbial Colonies: Unveiling the Secrets of Microbiological Science. Generative AI.
作品情報
Microbial Colonies: Unveiling the Secrets of Microbiological Science. Generative AI.
- ID:217179366
- 作品種別:
- 作者名:payphoto
キーワード
- agar
- analysis
- bacterial
- bacteriology
- biology
- biotechnology
- colony
- contamination
- culture
- danger
- disease
- dish
- environment
- experiment
- fungal
- germ
- growth
- health
- hygiene
- infection
- laboratory
- life
- medical
- medicine
- microbial
- microbiology
- microorganism
- molded
- mycology
- organism
- plate
- research
- rotten
- sample
- science
- scientific
- spoiled
- spore
- white
類似作品
close-up of vib...
Close up petri ...
Glowing colonie...
Generative AI :...
A close-up of a...
Backgrounds of ...
Close up petri ...
bacterial colon...
Backgrounds of ...
Close up petri ...
close-up of col...
Backgrounds of ...
Petri dishes co...
Various types o...
microbial cultu...
In the microsco...
Backgrounds of ...
bone marrow sam...
Close up of bac...
Explore the uns...
Microbiology Sc...
This vivid view...
petri dish with...
Various types o...
The mesmerizing...
Microscopic bac...
Characteristics...
Colorful variet...
Top view of a p...
Petri plate wit...
spreading of a ...
close-up of bac...
Air bubbles ins...
petri dish with...
Backgrounds of ...
microbial cultu...
Backgrounds of ...
A petri dish wi...
The mesmerizing...
close-up of vib...
Microscopic vie...
microbial cultu...
Metallic drop o...
Futuristic Petr...
The mesmerizing...
Close-up of a s...
Bacteria in a p...
Backgrounds of ...
A close-up of p...